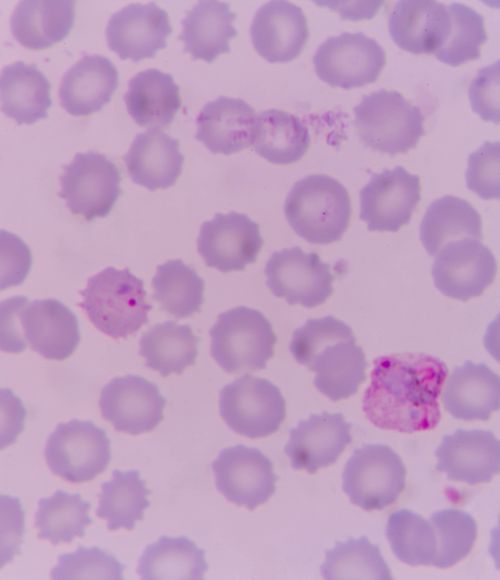
Malaria testing in Guyana

Rohan is passionate about creating real-world impact through genuine conversations with people that elicit deep insights and tangible outcomes.
An experienced practitioner in human centred design applications, Rohan brings a deep experience in conducting and facilitating user research, understanding and collecting user insights and translating research outcomes into innovative solutions. He is also a skilled visual designer and communicator, whose deep understanding of the design process enables him to methodically work through complex, multifaceted problems.
Rohan has a keen interest in applying his skills in development contexts, having worked in ThinkPlace’s office in Nairobi for several months. While in Kenya, he assisted with establishing ThinkPlace in a rapidly developing market and building international networks in the design and innovation space.
Rohan’s background is in Industrial Design and he has also completed a Masters in design-led innovation. His academic work was based in the manufacturing sector, where he applied design techniques to build an innovation culture within a medium-sized manufacturing company and to explore potential business model innovations. Rohan has presented various aspects of his academic research at several international design and business conferences in Shenzhen, Melbourne, Helsinki and London.
Rohan has completed training in Lean Six Sigma (greenbelt), PRINCE2 Project Management, and UX Design.